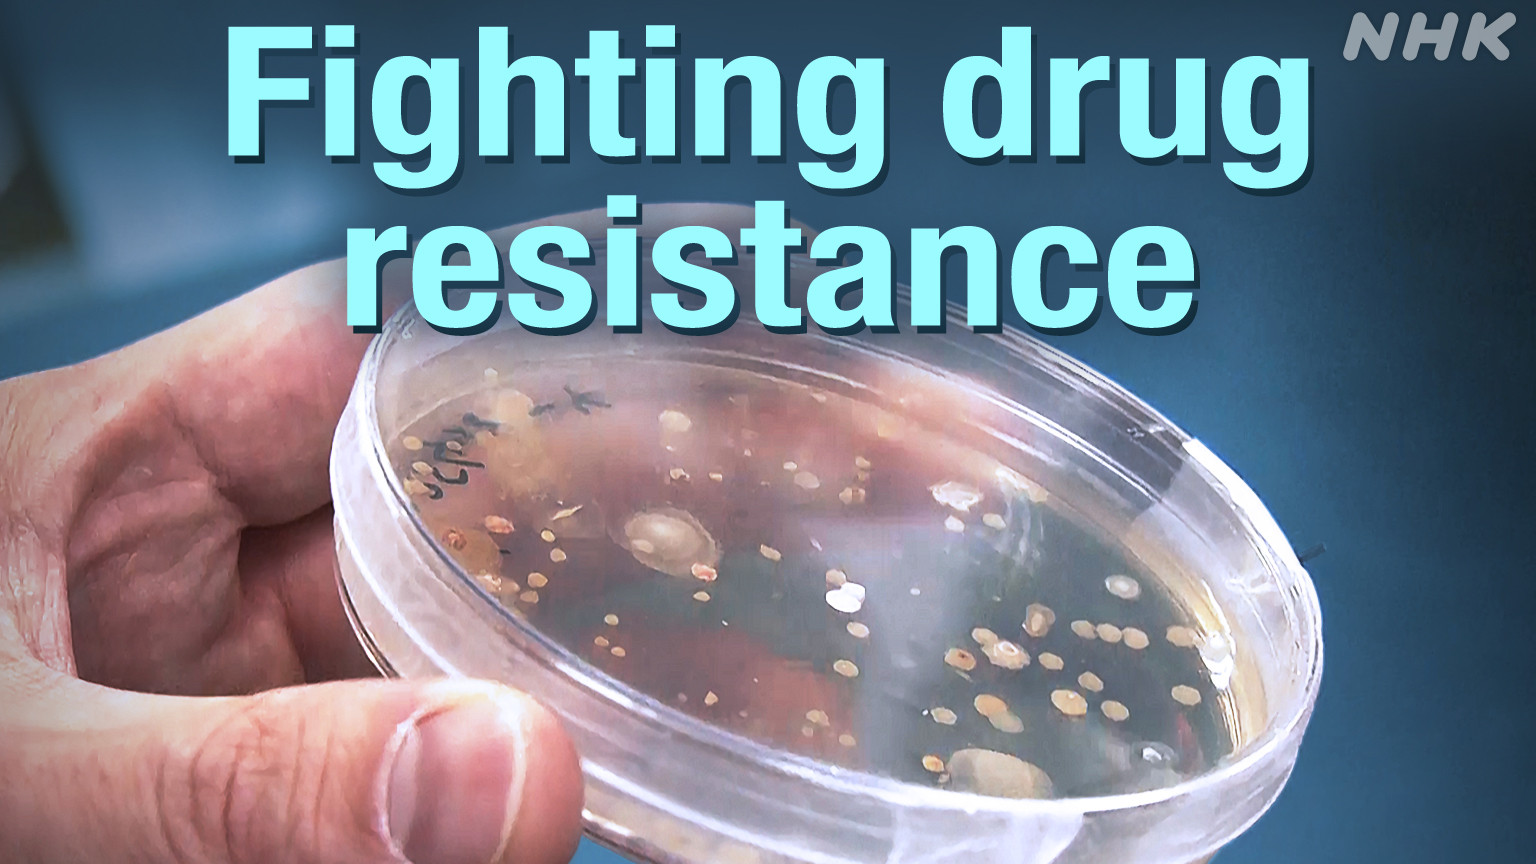
Ilmuwan Berpacu Melawan Resistansi Obat: Ancaman Global Menuju 2050

NHK
Visual tidak tersedia
Lawan Fitnah Internet, Permohonan Identifikasi Pelaku di Jepang Melonjak 70 Persen
Sistem hukum baru di Jepang kini memudahkan korban pencemaran nama baik untuk mengungkap identitas pelaku melalui perintah pengadilan. Data Mahkamah Agung mencatat lonjakan hingga 6.779 permohonan tahun lalu, meningkat pesat dari tahun sebelumnya.